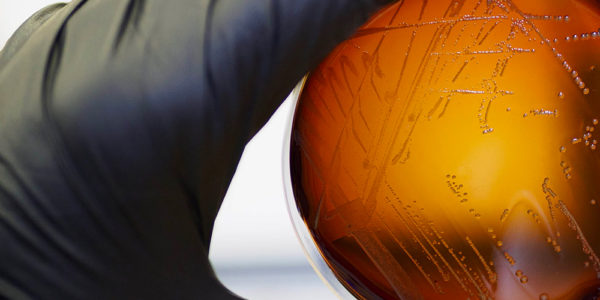

About Franz Weis
Managing Director e Co Responsabile delle strategie azionarie Europee
Comgest
Latest Articles
Commento Comgest: Azionario Europa – come proteggersi dalla volatilità?
mercati
La prima metà del 2025 per i mercati azionari europei può essere suddivisa in due trimestri distinti. Nel primo trimestre,……
Commento Comgest: Azionario Europa – il punto sui settori da monitorare
mercati
I mercati europei hanno registrato una buona performance nel mese di maggio, sostenuti dall’allentamento delle tensioni commerciali tra Stati Uniti……
Commento Comgest: Evitare la Value Trap a lungo termine
news
Fare troppo affidamento sui bassi rapporti P/E può condurre gli investitori in una pericolosa “trappola del valore”, che li porta……
Commento Comgest: Azionario Europa, su quali settori puntare
mercati
I mercati azionari europei sono stati estremamente volatili nel corso di aprile. Il “Liberation Day” ha inizialmente portato a una……
Europa, opportunità di crescita a lungo termine nell’ai
mercati
Il 1° trimestre è stato complesso pur essendo iniziato in modo molto positivo. Inoltre l’incertezza politica legata all’amministrazione Trump ha……
Azionario europa prosegue su una nota positiva
mercati
I mercati azionari europei hanno proseguito l’inizio anno positivo, realizzando un ulteriore rialzo a febbraio. Tuttavia, l’incertezza politica legata al……
È questo un buon momento per lo stile quality growth?
news
Spiccano le società quality growth A cura di Franz Weis, Analista & Gestore Azionario Europeo Le società europee quality growth……
In Europa il focus rimane investire sulla qualità
finanza
Nel 2022 l’inflazione è tornata con prepotenza, i tassi di interesse sono aumentati e, almeno teoricamente, la crescita è ripresa.……
Europa, focus su lusso e healthcare
finanza
Dopo un 2022 difficile, abbiamo assistito ad un bel recupero nei primi mesi del 2023, sostenuto da una combinazione di……
Azionario Europa, focus su healthcare e semiconduttori
mercati
Dopo un 2022 difficile, l’indice MSCI Europe è rimbalzato nella prima metà del 2023. L’inflazione e i tassi d’interesse continuano……